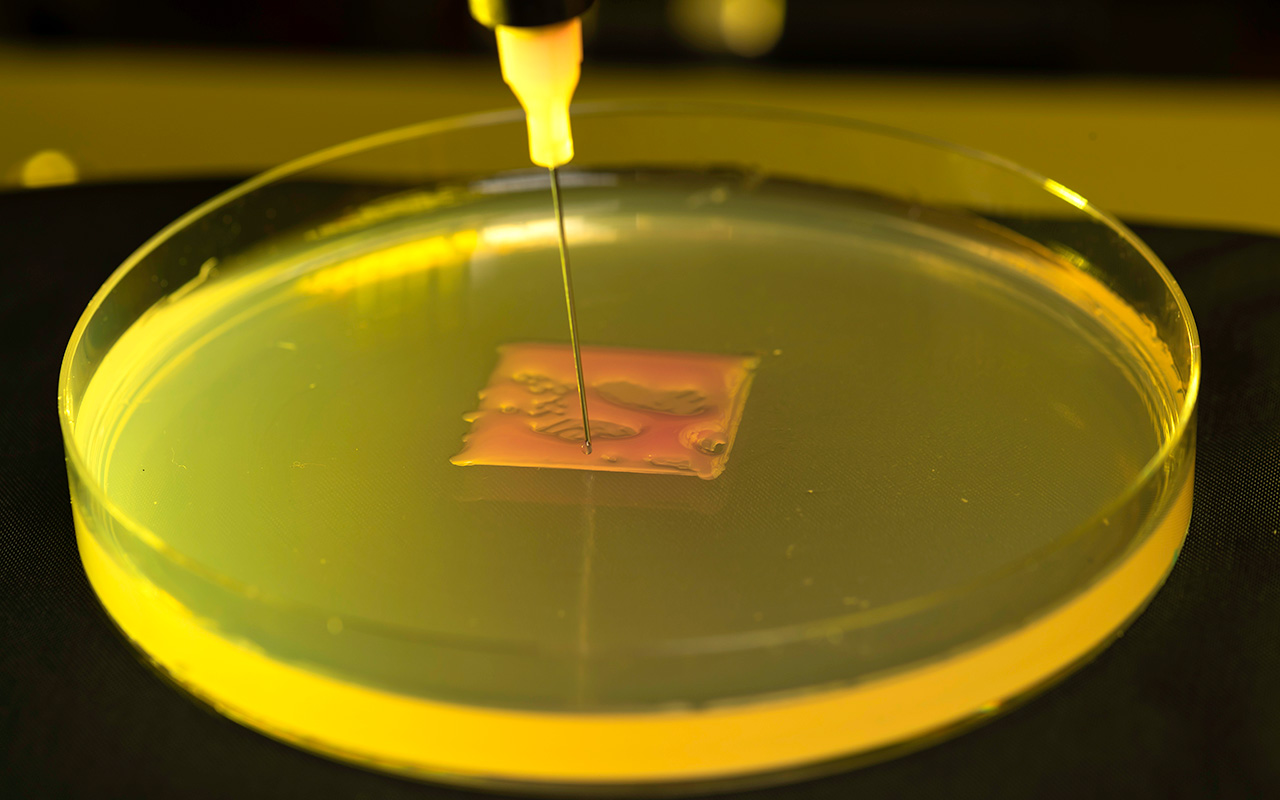
3D printer nozzle deposits biological material in a petri dish, representing research in printing living materials and biofilms.

We all should keep asking that question, if for this reason only: The University of Rochester’s answers get ever better.
Start with economic growth. We’re upstate New York’s largest employer, with a multiplier effect of some 30,000 jobs across the state. And of course there’s the clear educational task—fostering a future Renée Fleming, the next fusion energy pioneer, the next great biotech entrepreneur. It’s no accident that this University has produced 13 Pulitzer Prizes, 12 Nobels, 77 Grammys, and even two Guinness World Records.
Then there are the tangible results. Contributions by URochester students, faculty, staff, and alumni over the past 175 years have been making our lives richer, healthier, filled with music, enlightened. In the pages that follow, some of the items may surprise you, from Avatar’s native language to anabolic steroids, from the volunteer military to metal that refuses to sink.
These gifts to the world offer proof of the University’s philanthropic leverage. A dollar contributed to URochester seeds more than a single investigator, building, or experiment; it can lead to profound, positive change. Innovations that emerge from our laboratories, clinics, performance spaces, and classrooms continue to transform optics, nursing, galactic imagery, music, materials science, even the way major corporations are run. All in the pursuit of making the world ever better.
So, congratulations! As a reader of this magazine and a member of the URochester community, you share the credit for one of the world’s great resources. At the same time, we all have an increasingly urgent obligation to spread the word. Meliora is more than a wish or ambition for us; it’s a living, global, inspiring actuality.
And so we bring you this evidence-based survey, a cross-section of the indispensable research university.
—The Editors
With contributions by David Andreatta, Alison Arnold, Luke Auburn, Karen Black, Matt Cook, Gianluca D’Elia, Jay Heinrichs, Sandra Knispel, Johanna Lester, Tama Miyake Lung, Mark Michaud, Leslie Orr, Erin Peterson, Melissa Pheterson, Sofia Tokar, and Lindsey Valich. Illustrations by James Joyce.










































 88. If we target cancer cells, can radiation cause less damage?
88. If we target cancer cells, can radiation cause less damage?
 93. What does sleep do besides just give us rest?
93. What does sleep do besides just give us rest?

132. Because well-being comes from letting people rule themselves.
132. Because well-being comes from letting people rule themselves.



 143. Because something nuts can inspire a new field of human behavior.
143. Because something nuts can inspire a new field of human behavior.




















